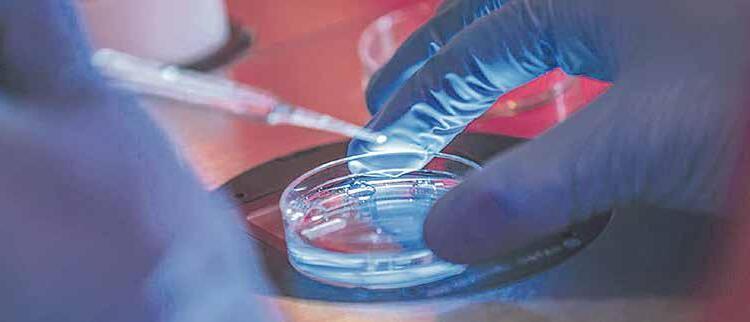

BANCOMER
CREATOR COMUNICACIÓN, S DE RL. DE CV. PERIODICO SEMANARIO
CUENTA PARA DEPOSITOS
01 58 98 90 44
INTERBANCARIA (TRANSFERENCIAS)
01 23 20 00 15 89 89 04 40









![]()
BANCOMER
CREATOR COMUNICACIÓN, S DE RL. DE CV. PERIODICO SEMANARIO
CUENTA PARA DEPOSITOS
01 58 98 90 44
INTERBANCARIA (TRANSFERENCIAS)
01 23 20 00 15 89 89 04 40









P BRO . A RMANDO G ONZÁLEZ E SCOTO
Uno de los círculos viciosos más comunes en el sacramento de la reconciliación es acusarse siempre de lo mismo, no por el hecho de que hagamos siempre lo mismo, sino porque nos acostumbramos a pensar que sólo es pecado aquello en lo que habitualmente incurrimos. Esta actitud nos ciega frente a muchas otras que acaban pasándonos desapercibidas y que pueden ser faltas igualmente graves.
Desde hace ya bastantes años el magisterio eclesiástico comenzó a hablar de pecados sociales, es decir, acciones que cometemos todos como comunidad en la medida que con o sin previo acuerdo asumimos las mismas actitudes ante los mismos hechos, por ejemplo, la indiferencia ante el sufrimiento ajeno, o considerar que las desigualdades sociales son naturales e inevitables.
También podemos detectar pecados estructurales, o un manejo indebido de nuestras acciones en las estructuras eclesiales, algo así como hacer como que hacemos cuando en realidad no hacemos nada, cumplir por cumplir, o limitarse a los mínimos.
El nuncio apostólico Christophe Pierre decía que en México nos gusta mucho hacer organigramas con todos sus casilleros, poner responsables en cada uno, y olvidarnos después de los resultados, el objetivo no es entonces alcanzar tales o cuales metas, sino sólo completar el casillero y desde luego mostrarlo a quien se interese: “ya cumplí”.
En diversas ocasiones tales como recibir visitantes distinguidos de la Iglesia se busca sólo llenar el expediente del modo que sea, y acarrear a quien se pueda, para como luego se dice, “dar el gatazo”.
Algo parecido sucede con la aplicación del plan diocesano, cuyo proceso algunas personas o no lo siguen o llenan los cuestionarios sobre el escritorio, “porque hay que entregarlos”.
Para el presente año santo se programaron con todos los requisitos de espacios y tiempos, jubileos de tales o cuales sectores de la sociedad, ya ha habido algunos, y de éstos también algunos fueron patéticos, pero “se cumplió”, otra vez, la fatídica frase que todo lo justi ca. Pero estos resultados magros demuestran que hay cosas que no se pueden improvisar o que hay acciones que no se están cumpliendo, porque pensamos que basta con hacer como que hacemos, hasta que los resultados nos delatan.
Pudiéramos preguntarnos, ¿será que nadie se da cuenta, o todos terminamos por hacernos de la vista gorda, porque eso de hacer como que hacemos resulta muy cómodo y evita problemas?
Contentarnos con lo que sea, con lo que salga y como salga, es propio de personas y sociedades decadentes, también de personas deshonestas, de individuos que aceptan responsabilidades para las cuales no tienen capacidad, pero les atrae el título; toda esta serie de conductas, actitudes e in nitas omisiones, exigen necesariamente de una puri cación cuaresmal, lo cual incluye que quienes tienen el deber de pedir cuentas, las pidan y lo hagan puntualmente, sin contentarse con informes vagos y resultados de “más o menos” ¿O no va por ahí el desierto cuaresmal?
armando.gon@univa.mx

Toque de agonías
El “garrote político” contra Canadá y México. Trump con los aranceles interrumpe el comercio entre los países al aumentar los impuestos sobre los bienes importados, y estos se trasladan a los consumidores a través de precios más altos. Pero, además, Trump promete aranceles a los productos agropecuarios. No bastó la ofrenda de extradición de 29 personas que estaban detenidas como parte de la delincuencia organizada. Entre ellos, están Rafael Caro Quintero, y Antonio Oseguera Cervantes, conocido como “Tony Montana”, hermano de Nemesio Oseguera Cervantes, líder del Cártel Jalisco. La incertidumbre que ya es permanente, se lee en el rostro de la presidenta de México, en sus conferencias mañaneras.
Toque a Campana Tañida
Se rompe con la práctica democrática de México realizada desde los años 90, en el que ciudadanas y ciudadanos cuentan los votos en el lugar donde se vota. Ahora, los votos serán llevados a centros electorales donde se contarán. Así, el Tribunal Electoral de la Federación con rmó la decisión del Instituto
P BRO . J OSÉ M ARCOS C ASTELLÓN P ÉREZ
El pasado jueves 20 de febrero, en las instalaciones del Seminario de Misiones, en el poblado de López Cotilla, se llevó a cabo una reunión que congregó a Vicarios Episcopales y Decanos de nuestra Iglesia particular. Dicha reunión fue convocada y dirigida por el Equipo de la Vicaría de Pastoral de Guadalajara.
Mientras un grupo de Decanos, los últimos en ser nombrados, recibían una capacitación para ejercer con responsabilidad creativa la misión encomendada; otros, discernían sobre las tareas más importantes del Decano, como son las visitas a las parroquias y la animación del proceso pastoral diocesano.
Los Vicarios Episcopales, por su parte, reflexionaron y discernieron sobre los equipos eclesiales en la organización pastoral de los Decanatos y
Nacional Electoral, el INE, de que no sean personas ciudadanas en casillas quienes cuentan los votos en la elección del próximo 1 de junio, cuando de manera extraordinaria se elegirán personas juzgadoras en todo México.
¿ Por quién Doblan las Campanas ?
Invocando el “interés superior de la niñez”, la Suprema Corte ha resuelto que Jalisco debe armonizar sus leyes, para permitir que niñas y niños, así como adolescentes, decidan si cambian su identidad sexual en sus actas de nacimiento, debido a que las personas trans se dieron cuenta de su identidad de género en su primera infancia. Lo que se plantea son cambios en el Código Civil para que en los registros aparezca con qué sexo quiere identicarse esa persona. ¿Una persona menor de edad está en condiciones para tomar una decisión jurídica de esa naturaleza? Los diputados, tienen la responsabilidad de legislar de manera informada y no sólo bajo la presión de que caerían en desacato.
Tan Tan Tan Tan fraybadajo@gmail.com
Vicarías territoriales. Por su misma identidad, tanto el Decanato como la Vicaría Episcopal tienen dos quehaceres fundamentales: el primero es la formación integral y permanente, así como la fraternidad del presbiterio; el segundo, la animación y organización pastoral subsidiaria para que se logre, en todo el territorio diocesano, una pastoral orgánica y de conjunto.
Para atender la primera tarea, estas instancias eclesiásticas, el Decanato y la Vicaría Episcopal, se organizan y coordinan por aquellos que son nombrados por el Obispo para presidirlas, es decir, el Vicario Episcopal, los Decanos y Subdecanos, incluso los secretarios de dichas instancias. Para la segunda tarea, la de animar y organizar la vida pastoral, se invita a que en todos los Decanatos y Vicarías Episcopales haya participación y representación de la vida consagrada y de los laicos; lo que comúnmente llamamos “Equipo Eclesial”. Se re exionó y discernió precisamente sobre la importancia de la representación, en el marco de la eclesiología de comunión y participación. El presbiterio del Decanato o de la Vicaría está representado precisamente por el Equipo Nato. Los laicos y miembros de la vida consagrada son representados por aquellos que, desde su parroquia, participan corresponsablemente en la vida eclesial y en la acción pastoral de la comunidad parroquial; nunca al margen de la parroquia. La representación, especialmente de laicos, se da en círculos concéntricos: primero y central en el Equipo Coordinador Básico de la parroquia, en el que representan a su pequeña comunidad, equipo o grupo. En segundo lugar, el equipo decanal de las distintas áreas de la acción pastoral, que alguna vez sería convocado y consultado por el Equipo Nato, resultando de esta convocación el tercer círculo.
Esta forma de entender la eclesialidad nos compromete más que el mero convocar laicos y religiosos a juntas con tinte de compadrazgo y con la tentación clericalista para cumplir con un buen propósito, muchas veces sin objetivo alguno. Se trata, más bien, de apostar por una pastoral de conjunto que busca fortalecer la vida pastoral de la parroquia con la ayuda subsidiaria de los equipos decanales y vicariales de las distintas dimensiones de la pastoral. Esto permite una mayor riqueza y representación desde la base misma que es la parroquia y potenciar de forma especí ca y cuali cada cada dimensión de la vida pastoral.
Semanario Arquidiocesano de Guadalajara
• Órgano de Formación e Información Católica • Semanario Arquidiocesano de Guadalajara, fundado por el Sr. Cardenal Dn. Juan Sandoval Íñiguez, el 24 de enero de 1997 Registrado ante la Comisión Calificadora de Publicaciones y Revistas Ilustradas —CCPRI— en Certificados de Licitud de Título y Contenido números 10296 y 7226 expediente 1/432“97”/13565 el 20 de enero de 1998 y en el Instituto Nacional de Derecho de Autor, bajo reserva al uso exclusivo del título 04-2018-021211450400-101 el 12 de febrero de 2018 Registro Postal Publicación Periódica PP14-0002-2000, autorización por SEPOMEX • No se devuelven originales. Los escritos firmados son responsabilidad del autor, no de la publicación ni del titular • Es una publicación editada por Creator Comunicación, S. de R.L. de C.V., con oficinas y redacción en Isla Flores N. 3344-2, Col. Jardines de San José, Guadalajara, Jal., México, C.P. 44950 A.P. 3-31. Los anuncios que se muestran en Semanario son responsabilidad, única y exclusivamente, del solicitante. No nos hacemos responsables de los servicios que se publicitan.
Teléfono: 3002-6470. Suscripciones: Ext. 1954 | Publicidad: Ext. 1906+1925 | Redacción: Ext. 1922 Horario de oficina: 8:30 a.m. a 5:30 p.m., correo electrónico: semanario@cccomunicaciones.com.mx Página Internet: http://www.semanario.com.mx Distribución: Mensajería Tercer Milenio. Impreso por: Creator Comunicacion S. de R.L. de C.V. con oficinas en Isla Flores N. 3344, Col. San José, Tlaquepaque, Jalisco. Tel. 3002-6470. ventas.creator@cccomunicaciones.com.mx
No es fácil entender el por qué del sufrimiento, mucho menos aceptarlo. Sin embargo, tenemos ejemplos brillantes, no siempre vienen de los santos, sino de personas sencillas, piadosas, comprometidas con la Iglesia y unidas plenamente a Jesucristo en la Eucaristía. Se llamaba María del Rosario. Esposa, madre de familia, encargada de una capilla y catequista. Incansable mujer. A cada enfermedad que le iba llegando, la consideraba un regalo del Señor. Se le oyó decir: “Acepto ese regalo, pero dame fuerzas para no renegar...y te ofrezco todos mis sufrimientos por la salvación de mi alma y la de mis hijos”.
Parecería que había leído los escritos del Papa san Juan Pablo II o de Francisco. El Papa de Polonia había dicho en más de una ocasión: “el sufrimiento es una prueba de fe y un acto de amor...en Cristo sufriente la humanidad halla el signi cado de los propios padecimientos. El hombre aun realizando todo esfuerzo para combatir y eliminar el sufrimiento debe convencerse de que éste no es una derrota sino una buena prueba de fe y un acto de amor”. Y vaya que sufrió mucho quien antes de ser Papa llevó el nombre de Karol Wojtyla y murió, como diría el escritor español Alejandro Casona, “de pié, como los árboles”. Dejando una enseñanza de fortaleza ante el dolor, por estar unido al Divino Maestro. Por su parte, Francisco, en su encíclica Lumen Fidei expresó: “En el momento del sufrimiento la fe es más fuerte...el cristiano sabe que siempre habrá sufrimiento, pero que le puede dar sentido, puede convertirlo en acto de amor, de entrega con ada en las manos de Dios, que no nos abandona y, de este modo, puede constituir una etapa de crecimiento en la fe y en el amor”. También dice el Papa de origen argentino, en estas semanas agobiado por el dolor: “la luz de la fe nos lleva a olvidarnos de los sufrimientos del mundo, pues personas de fe como san Francisco de Asís y santa Teresa de Calcuta han recibido la luz de las personas que sufren. Ellos han captado el misterio que se esconde en ellos, no les han quitado todos sus sufrimientos, ni han podido dar razón cumplida de
todos los males que los aquejan. La luz de la fe no disipa todas nuestras tinieblas, sino que, como una lámpara, guía nuestros pasos en la noche, y esto basta para caminar. Al hombre que sufre, Dios no le da un razonamiento que explique todo, sino que le responde con una presencia que le acompaña”. Y mientras muchas personas, familiares, amigos, conocidos, sufren en los hospitales, santuarios del dolor, ha llegado la Cuaresma. Oportunidad para orar por los enfermos. Ocasión para re exionar sobre el sentido del sufrimiento que, tarde que temprano nos visitará y, frecuentemente nos acompañará hasta el n de nuestra vida. Santa Teresa de Jesús de los Andes llegó a decir: “El sufrimiento no me es desconocido. En él encuentro mi alegría, pues en la cruz se encuentra Jesús y Él es amor. Y, ¿qué importa sufrir cuando se ama?”.


Hermanas y hermanos en el Señor:
Dios nos mira con amor y nos participa de su Espíritu para ser presencia suya en medio de los demás.
Debemos prepararnos para recorrer este camino cuaresmal. Es una invitación personal para llegar a la Pascua, es una invitación particular para la realidad que vive cada quien, un llamado a la conversión, pero al mismo tiempo es un llamado a la comunidad como pueblo de Dios.
Que todos podamos vivir a plenitud, en este tiempo de conversión, nuestra dignidad de hijos de Dios.
El mensaje del Papa Francisco para el periodo cuaresmal de este año es: Caminemos juntos en la esperanza.
En primer lugar, el Papa quiere, con este tema, envolver el Año Jubilar que estamos viviendo en la Iglesia con la virtud de la esperanza cristiana y, al mismo tiempo, asume la vertiente que ha acentuado en su ponti cado, que es la sinodalidad. La Iglesia es una comunidad sinodal.
Nos reta a que nos revisemos en lo personal y en lo eclesial cómo vivimos





esta nota esencial de la Iglesia, porque si no lo experimentamos, no será sino solo doctrina, pero no realidad.
El Papa nos invita a caminar, a redescubrir nuestra condición de peregrinos, a semejanza del pueblo de Israel, en el Éxodo. Dios sacó a su pueblo de la esclavitud hasta llevarlo a su tierra.
Esta experiencia del pueblo elegido es también nuestra realidad. No vamos a quedarnos para siempre en este mundo, sino que vamos caminando. El recorrido es difícil, como es la vida. Parte de una realidad de esclavitud y sometimiento a una realidad de libertad.
Podemos caminar por la vida como esclavos, sometidos a muchas cadenas, o caminamos libre hacia una plena libertad.
Francisco nos recuerda que no podemos dejar de pensar en el éxodo bíblico sin tomar en cuenta a tantos hermanos que hoy huyen de su situación de miseria o de violencia buscando una vida mejor. Esta realidad nos sugiere una llamada a la conversión, porque todos somos peregrinos en la vida. Nos debemos preguntar: ¿Cómo me dejo interpelar por esta condición de errante?
¿Estoy en camino o paralizado, estático, con miedo, con falta de esperanza? A lo mejor me siento satisfecho en una zona de confort. ¿Busco caminos de liberación de las situaciones de pecado o permanezco ahí?
Además, el Papa nos llama a saber escuchar, incluso a los que sabemos que están mal (sin dejar de pensar que nosotros también lo podemos estar, aunque en otra circunstancia). No debemos rechazar a alguien así nomás por nomás. Encontrarnos con alguien que vive mal puede ser la ocasión para escuchar que nos platique la tragedia interior que vive, porque sabe que no está como quiere Dios, y que no lo puede dejar.
Les haremos mucho bien si dejamos que nos expresen su sentir y que se lleven de nuestra parte un mensaje de consuelo, de esperanza y de motivación para buscar la solución a su problema, que son conscientes que lo tienen.
La sinodalidad no es para caminar juntos los que supuestamente somos buenos, sino para corregirnos juntos, en lugar en el que estamos.
El Señor nos llama a que esperemos y luchemos por enmendar y mejorar nuestra vida.
Yo les bendigo en el Nombre del Padre, y del Hijo y del Espíritu Santo.


A DRIÁN A GUILERA A.
Hace unos días, la Suprema Corte de Justicia de la Nación, volvió a noti car al Congreso de Jalisco para que modi quen la Ley Estatal del Registro Civil, a favor de las infancias trans, esto con la nalidad de que los menores de edad, puedan cambiar de género y nombre en su acta de nacimiento cuando así lo quieran, justicando que están atendiendo el interés superior de la niñez.
Los que promueven dicha reforma, consideran el derecho a que se reconozca la autopercepción en materia de género como vinculante para las instancias de gobierno, particularmente para el Registro Civil. En este momento la iniciativa está a la espera de ser presentada en el pleno para su discusión y votación, cosa que podría acontecer en cualquier momento.
Este tipo de iniciativas, de gran trascendencia e impacto en nuestra




• Los niños necesitan, antes que otra cosa, de adultos responsables que les brinden cariño, seguridad y orientación. El papel de las familias —familias sanas y protectoras— es imprescindible y ninguna ley debería vulnerarla ni debilitarla.
• Hay que precisar que la iniciativa en cuestión atenta gravemente en contra de la patria potestad al prever que, si los padres no estuvieran de acuerdo con los deseos del niño en esta materia, un representante de la procuraduría para la protección de niños, niñas y adolescentes, se hará cargo de que el proceso tenga lugar.
• La Iglesia enseña que, para nosotros, cristianos, uno de los principios no negociables en la esfera pública es el reconocimiento del derecho de los padres a decidir sobre la educación y orientación moral de sus hijos.
sociedad, deben analizarse bajo dos cuestiones básicas: la primera tiene que ver con el fondo, y la segunda, con la forma de la propuesta.
¿ PUEDEN DECIDIR?
En cuanto al contenido que los niños y adolescentes puedan de nir su identidad en documentos o ciales, primero se debe realizar una modi cación al reglamento del Registro Civil. Ahora, lo que se pretende es convertirla no solo en un procedimiento, sino otorgarle el carácter de ley.
Hay que considerar en este punto, por lo menos, cuatro aspectos preocupantes: ¿pueden los niños asumir las
implicaciones y consecuencias de una decisión tan trascendente?, ¿pueden hacerlo sin el permiso y la supervisión de quienes por ley natural están obligados a cuidarlos y buscar lo mejor para ello, es decir, de sus padres?, ¿la autopercepción en materia de género es motivo su ciente y vinculante para las instituciones de gobierno?, ¿qué podemos esperar?
Es decir, ¿qué seguirá si se abre esta puerta?, ¿se obligará a otras instancias gubernamentales, a las que prestan servicios de salud, por ejemplo, a ponerse al servicio del cambio de identidad?
Una legislación que pretenda prestar un servicio al bien superior de los menores debe de tener en cuenta que solo
progresivamente un menor va aprendiendo a hacer un uso responsable de su propia libertad, lo cual supone la toma de conciencia de las consecuencias de las elecciones y decisiones.
No se puede pretender, sobre todo a cierta edad, que el niño asuma la carga de tomar decisiones, en cierto sentido irreversibles, sin la supervisión de quienes por ley natural están llamados a custodiarle y brindarle todos los elementos necesarios para su sano desarrollo.
Razón por la cual, si se quiere legislar en materia que afecta a los niños, se deben precisar con mucho cuidado las prerrogativas propias de cada edad, atendiendo a los resultados seguros de

la psicología evolutiva y de las demás ciencias del desarrollo, y en función de los datos que nos ofrecen los especialistas, establecer protocolos para acompañar a los padres y a las familias en cualquier proceso que tenga que ver con el desarrollo integral de niños, niñas y adolescentes.
En el Congreso de Jalisco se estudia la propuesta de reforma al Artículo 23, fracción VIII, de la Ley del Registro Civil del Estado de Jalisco, será interesante saber, cómo votan nuestros diputados.
Por otra parte, se incurre en un grave equívoco al identificar la así llamada, “conciencia de género” con la conciencia de sí mismo, pues aquella no es sino un elemento, y no el único ni el más importante, en relación con la percepción progresiva de la propia identidad. La conciencia de sí mismo es un proceso de toda la vida, que no termina nunca, y en el que intervienen muchos factores. Simplificar los elementos que influyen en este proceso y pensar que a una edad determinada ya está del todo concluido, termina reduciendo a la persona a una mera caricatura. Pensar que la propia realidad biológica puede ser ignorada sin que haya consecuencias no es ciencia, sino mera ficción: una hipótesis peligrosa que tarde o temprano termina por dejar a las personas en el vacío.
RESPONSABILIDAD EMOCIONAL
Hay que estar atentos y enseñar a nuestros niños, desde la más tierna infancia, a gestionar adecuadamente sus emociones y deseos. Para ello, es imprescindible un ambiente que les ofrezca seguridad. Responsabilidad no pequeña en la formación de esta comunidad de apoyo emocional, social y moral, la
tienen los padres, a los que el Estado debe respetar y para los cuales ha de poner a disposición los medios necesarios, a fin de que estén capacitados para acompañar y atender a sus hijos pequeños, sobre todo, si se encuentran en una situación de especial vulnerabilidad.
Pensamos, no sin fundamento que, si se abre esta puerta, muy pronto se buscará dar un siguiente paso. Efectivamente, no se habla todavía de poner a disposición de los niños los supresores de pubertad ni las así llamadas cirugías de reasignación de sexo; pero si se comienza por reconocer el derecho de cada uno a que la propia autopercepción genere obligaciones no negociables para el Estado, es lógico esperar que luego este tenga que responder a las exigencias de quienes, no contentos con su apariencia, reclamen que las instituciones de salud les ofrezcan los medios
para cambiarla. El panorama mundial nos muestra que los pasos van siempre en esa dirección.
El legislador que ha presentado la propuesta ha decidido no incluir en ella un tema todavía más polémico, en el que la opinión de los especialistas es un “no”, rotundo. Debido a las consecuencias de dichos procedimientos, no son pocas las asociaciones médicas a lo largo y ancho del mundo que han expresado un contundente rechazo a dicha alternativa.
¿Al acceder en una materia en que la opinión de los especialistas es contundente, y la del público en general se divide de manera tan dramática, no estamos tratando a los niños y niñas como si fueran un material para hacer experimentos que pueden resultar peligrosos?, ¿en un asunto tan delicado no estaremos obligados, por lo menos, a adoptar una actitud responsable y paciente, sin obviar los procesos, ni saltarnos ni uno solo de los pasos que recomienda la prudencia más elemental?

9 de Marzo de 2025
A DRIÁN A GUILERA A.
En cuanto a los vicios que han tenido lugar en el proceso en torno a la discusión de esta iniciativa, se puede hablar de dos: se habían propuesto una serie de foros en los que intervinieran especialistas para que, con argumentos sólidos y bien fundamentados, se arrojase luz sobre las distintas implicaciones y consecuencias que trae consigo un asunto tan complejo, y en el que hay que tener en cuenta varias aristas. De buenas a primeras, dichos foros fueron cancelados.
La otra cuestión procedimental que resulta no solo llamativa, sino incluso ofensiva, es la arbitraria y unilateral determinación de pasar la discusión de la Comisión de puntos constitucionales a la Comisión de Igualdad Sustantiva.
Esta decisión no solo va en contra de las disposiciones legales vigentes, sino que además cierra toda posibilidad ulterior de diálogo. Es, por poner un ejemplo, como si una polémica relacionada con un partido Chivas - América, en lugar de ser revisada por una comisión imparcial de arbitraje, quedase más bien en manos de una comisión de americanistas. La votación ulterior será un mero simulacro.
Los legisladores justifican sus acciones diciendo que los derechos no se pueden someter a consulta, ni discutirse. Pero, al a rmar este supuesto derecho, ¿no estarían siendo pisoteados otros más fundamentales?, ¿dónde queda el derecho de los niños a quedar al margen de pugnas políticas e ideológicas, a no ser tratados como material de laboratorio, a que no se les someta a experimentos peligrosos?
¿Dónde el derecho de los padres y las familias?, ¿dónde el derecho a recibir una información completa y adecuada acerca de las implicaciones de elecciones en materia tan compleja?, ¿dónde el derecho de los ciudadanos a que sus representantes presten atención a sus justos reclamos?, ¿dónde el derecho, consagrado como cimiento de una sociedad democrática, a que todas las voces sean escuchadas y representadas en la toma de decisiones?
No es poco lo que está en juego en este asunto: es la vida de muchas personas, es la educación de los niños y su futuro, es la actitud y solicitud que como adultos hemos de adoptar ante personas

que están sufriendo. Como ciudadanos hemos de exigir nuestro derecho a ser escuchados y ejercer nuestra obligación de levantar la voz por los más indefensos y vulnerables, conscientes de que algún día hemos de dar cuentas a Dios de lo que hicimos o dejamos de hacer por cualquiera de estos más pequeños e indefensos.
En torno a este tema de las infancias trans, el pasado 21 de febrero, el Gobernador de Jalisco, Pablo Lemus Navarro, hizo una declaración a título personal en la que expresó su desacuerdo para legislar la Ley.
“No estoy de acuerdo en que, a las niñas y a los niños, como no debemos de darles la facultad a las niñas y niños de consumir alcohol o de consumir tabaco, de darles una decisión en torno a su género cuando no tienen la madurez sufi ciente para tomar esa decisión (…) nuestras diputadas y diputados deben de rechazar esta iniciativa”.
Insistió que es una decisión que los jóvenes podrán tomar una vez que cuenten con su mayoría de edad, no teniendo seis o siete años.
“Estoy de verdad totalmente en contra de darles la facultad a nuestras niñas y niños de elegir su género,
cuando no tienen la madurez suficiente para hacerlo, por eso me opongo a que las niñas y niños consuman alcohol o consumen tabaco, no están en edad de hacerlo, hay que cuidar a la niñez”.
Pablo Lemus destacó que en Jalisco se deben cuidar las infancias y hasta que tengan su mayoría de edad, podrán tomar sus propias decisiones.
“Lo que haga la Corte será otra cosa, pero aquí en Jalisco somos un estado autónomo y nosotros podemos tomar nuestras propias decisiones. En Jalisco se debe de proteger a la niñez (…) es mi posición muy personal, no se debe aprobar esto en el Congreso del Estado de Jalisco, porque la prioridad de nuestro Estado son las niñas y los niños”.
El gobernador también pidió a los diputados del Congreso, que la votación de la reforma de infancias trans no sea secreta, como ocurrió con el tema del aborto y el matrimonio igualitario, y que hagan público a la ciudadanía el sentido de su voto


ALFREDO ARNOLD
El pasado día 3 de marzo se cumplieron 90 años de la fundación de la primera universidad particular de México, la Universidad Autónoma de Guadalajara, surgida no de un plan de gobierno ni de una decisión de empresarios; la Autónoma nació a raíz de un movimiento estudiantil en contra de la educación socialista que pretendía imponer el gobierno.
El movimiento estudiantil estalló el 3 de marzo de 1935. Un nutrido grupo de estudiantes de la antigua Universidad de Guadalajara había tenido reuniones para acordar los pasos que darían en favor de la autonomía universitaria y la libertad de cátedra ante la amenaza de la instalación del socialismo, y aquel domingo 3 de marzo organizaron una manifestación en el centro de Guadalajara en la que fueron entusiastamente apoyados por la ciudadanía tapatía. Durante el intento oficial por reprimirla cayeron mortalmente heridos tres ciudadanos: José López, Salvador Torres y Crescenciano Núñez. Estos sucesos derivaron en la orden presidencial del general Lázaro Cárdenas del Río, quien tenía escasos tres meses en el gobierno, dada al gobernador de Jalisco Everardo Topete, de atender a los jóvenes manifestantes. El resultado de las pláticas fue casi inmediato. “¿Quieren una universidad?...Háganla!”
Por primera vez en la historia de México se retaba a un grupo de jóvenes a hacer una universidad, por supuesto sin ofrecerles ningún tipo de recursos.
Los jóvenes aceptaron el reto y realizaron gestiones para iniciar cuanto antes las clases. Obtuvieron el apoyo de la Universidad Nacional de México para dar validez a sus estudios profesionales, y en Guadalajara un buen número de profesionistas se ofrecieron para impartir clases. Los primeros edificios universitarios eran casas prestadas. Poco después, el señor Ramón Garibay les donó la casa donde hoy se ubica el hospital que lleva su nombre y que durante varios años fue sede de la Facultad de Medicina.
En poco tiempo, y bajo su primer nombre de Universidad de Occidente que sería sustituido por el de Universidad Autónoma de Guadalajara, dio sus primeros pasos la UAG.
Carlos Cuesta Gallardo, los hermanos Ángel y Antonio Leaño Álvarez del Castillo y Dionisio Fernández Sahagún, encabezan la lista original de fundadores de la UAG. Otros estudiantes pioneros son: Antonio Pérez, Daniel Salazar Hurtado, Joaquín Aceves, Porfirio Barba y Francisco López González, que formaban parte de la mesa directiva de la Federación de Estudiantes de Jalisco (FEJ).
Los hermanos Leaño eran hijos del Ing. Nicolás Leaño Vélez y Juana Álvarez del Castillo. Don Nicolás, además de ser un reconocido ingeniero civil, participó activamente en la política de Jalisco; algunas de sus propuestas laborales quedaron impresas en la Constitución de 1917. Ya fundada la UAG y al correr de los años se incorporó el más joven de los hermanos Leaño Álvarez del Castillo: el ingeniero Juan José, quien falleció hace tres años.
El Dr. Ángel Leaño murió muy joven, tenía 38 años de edad. En el jardín de Ciudad Universitaria a un costado de la Rectoría, una estatua lo recuerda. La Universidad, su familia y la defensa de los valores cristianos constituyeron el motor de su existencia. Murió el 12 de mayo de 1951. La UAG se fue desarrollando rápidamente mediante la creación de la preparatoria y nuevas carreras. La Facultad de Medicina, que hasta nuestros días es considerada como una de la mejores del país, ha propiciado la llegada de miles de estudiantes extranjeros. A finales del siglo veinte, el presidente de Estados Unidos George W. Bush le entregó un reconocimiento al Lic. Antonio Leaño Álvarez del Castillo por los miles de jóvenes estadunidenses formados en la UAG.
Antes de 1970 las facultades estaban dispersas por la ciudad y Lomas del Valle. Fue ese año cuando nació Ciudad Universitaria: una bella, extensa y funcional
construcción que, por cierto, detonó el desarrollo de Zapopan pues de ser una zona totalmente desierta, hoy es uno de los sectores más importantes de la Zona Metropolitana de Guadalajara.
Ligada a las más modernas prácticas universitarias, la UAG figura actualmente entre las principales universidades del país. Las instituciones particulares de educación superior se han multiplicado, pero la UAG conserva un sitio especial, se ha modernizado, tiene convenios con más de 300 empresas y universidades del mundo, ha abierto campus en otras entidades, tiene completa la cadena educativa desde primaria hasta posgrados y cuenta con una relación académica especial con Arizona State University. La UAG se sigue desarrollando, pero su filosofía no cambia; el espíritu de los fundadores permanece vivo.
LAE, diplomado en Filosofía y periodista. Académico de la Universidad Autónoma de Guadalajara.


dejó instrucciones y dinero, por ejemplo, para el Sagrario Metropolitano, aunque para otras obras sólo alcanzó a transmitir la idea. Su vida y obras forman parte del día a día en Guadalajara y de nuestra memoria colectiva, tan asumidas e integradas que poco nos detenemos a recordar su origen, casi no nos entretenemos en preguntarnos ¿quién lo hizo? ¿por qué? ¿cómo? ¿desde cuándo? Pero ahí están, en pie y funcionando como desde el primer día.
Todas las obras que pagó y promovió en la todavía capital de la Nueva Galicia (le tocó el cambio de provincias a intendencias con las reformas borbónicas) han trascendido a través del tiempo, sobrevivientes de siglos o en la memoria o en los libros.
Alcalde supo recibir y administrar los recursos de la diócesis de la que era responsable, con maestría y, sobre todo, con transparencia; la noticia de su muerte fue en realidad una rendición de cuentas. Siempre me llamó la atención el lujo de detalles que dejó en su relación pecuniaria. En la entrega anterior anuncié que presentaría en este espacio, de manera íntegra, la noticia de su muerte y procedo a cumplir con la promesa. Nos vamos por partes.
Es una transcripción fiel de la noticia que se publicó en 1793, se conservan la redacción y la ortografía originales; y es abundante e interesante toda la información que contiene.
ENOTICIA DE LA MUERTE,
PIEDAD EXEMPLAR Y ZELO PASTORAL
DEL RMO. É ILMO. SR. D. FR. ANTONIO ALCALDE,
DEL ORDEN DE PREDICADORES, OBISPO QUE FUE DE YUCATAN Y GUADALAXARA EN INDIAS.
n 7 de agosto de 1792 falleció en su Palacio Episcopal de la Ciudad de Guadalaxara este dignísimo Prelado, cuyas virtudes, zelo pastoral, y caridad ardiente con el próximo merecen referirse aquí para edificacion del público. Nació en 15 de Marzo de 1701 en la Villa de Cigales, del Obispado de Valladolid; á los 16 años tomó el hábito de Sto. Domingo en el Convento de S. Pablo de dicha Ciudad. Después de su profesion no fué ménos su cuidado en conseguir las virtudes religiosas propias de su instituto, que en dedicarse al estudio. En vista de sus progresos le nombró la Religion para Lector de Filosofía, y después de Teología, cuyas facultades enseñó por espacio de 26 años en varias casas principales ó estudios generales de esta Provincia con general aprobacion y utilidad de sus oyentes. En
atencion á su mérito se le confirió el grado de Maestro; fue electo Prior del Convento de Zamora, y despues de Jesus María de Valverde, donde florece la observancia primitiva de la Orden. Noticioso de su virtud y talentos el Señor Cárlos III, lo nombró Obispo de Yucatan en la Provincia de Campeche, al mismo tiempo que se hallaba electo Prior del muy religioso Convento de Sta. Cruz de Segovia; y habiendose puesto en manos del Emmo. Sr. Cardenal de Boxadors, Maestro General á la sazon de toda la Orden, estas dos elecciones, le mandó aceptar el Obispado, de que tomó posesion el primero de Agosto del año de 1763. Apenas empezó á exercer su ministerio pastoral, quando se viéron en él las prendas y virtudes que se admiráron en los Pastores de los primeros siglos. Su Palacio Episcopal parecía un Convento de los mas observantes en el recogimiento, oracion, humildad, modestia
y trage, tanto de su Ilustrísima, que nunca usó mas que el hábito de su Religion, como del corto y preciso número de sus familiares, á quienes hacia recogerse al toque de las oraciones, cerrando las puertas de Palacio y dedicándolos desde aquella hora al estudio y exercicios de devocion. Su mesa fué sumamente frugal, y servida de vaxilla de peltre comun. La vigilancia sobre su rebaño era continua: visitó dos veces á pie todo su Obispado, durmiendo en varias ocasiones en medio de los montes mas ásperos: confirmó mas de 2500 almas: predicaba en todas las Iglesias con la claridad y sencillez que previene el ceremonial de los Obispos: reformó y aumentó considerablemente su Clero; y enriqueció la Ciudad de Yucatan con muchas fundaciones piadosas, socorriendo á los pobres con quantiosas limosnas.

L uis s ánchez
En las últimas semanas, la comunidad católica mundial ha seguido con atención la evolución de la salud del Papa Francisco. Hospitalizado desde el 14 de febrero debido a una neumonía bilateral, su estado ha sido descrito como crítico, pero estable. A pesar de la gravedad de su condición, el Pontífice ha continuado con algunas de sus labores desde el hospital, demostrando su inquebrantable compromiso con la Iglesia y sus fieles.
La figura del Papa Francisco ha sido emblemática en la promoción de los derechos humanos y la justicia social. Su liderazgo ha inspirado a comunidades católicas en todo el mundo, incluyendo México, donde la Iglesia ha desempeñado un papel crucial en la defensa de los derechos fundamentales. En un país marcado por la violencia y la impunidad, la Iglesia Católica ha alzado su voz para denunciar las constantes violaciones a los derechos humanos. La Arquidiócesis de México ha enfatizado la importancia de no acostumbrarse a la “violación cotidiana” de estos derechos, subrayando la necesidad de una respuesta activa y comprometida por parte de la sociedad.
La relación entre la Iglesia Católica y la defensa de los derechos humanos en México tiene raíces profundas. Históricamente, la Iglesia ha sido tanto objeto
de persecución como defensora de los oprimidos. Durante la Guerra Cristera en la década de 1920, la Iglesia enfrentó una intensa persecución bajo leyes anticlericales que restringían la práctica religiosa y los derechos del clero.
A pesar de estos desafíos, líderes eclesiásticos continuaron abogando por la justicia y la dignidad humana.
En tiempos más recientes, la Iglesia ha mantenido su compromiso con la defensa de los derechos humanos. Tras el asesinato de un sacerdote en Chiapas en octubre de 2024, la Iglesia Católica intensificó su presión sobre el gobierno mexicano para abordar la creciente inseguridad y violencia en el país. Este trágico evento subrayó la valentía de los líderes religiosos que, a pesar de los riesgos, continúan defendiendo a sus comunidades frente a las amenazas del crimen organizado.
La salud del Papa Francisco, en este contexto, adquiere una relevancia particular. Su liderazgo ha sido una fuente de inspiración para muchos en la lucha por los derechos humanos. Su enfoque pastoral, centrado en la misericordia y la justicia, ha fortalecido a comunidades que enfrentan adversidades. Mientras el Papa se recupera, la Iglesia en México y en todo el mundo continúa su misión de promover la dignidad humana, recordando sus palabras: “No podemos permanecer indiferentes ante el sufrimiento; debemos responder con compasión y acción”.
Recientes actualizaciones indican que el Papa Francisco ha mostrado signos de mejoría. Según informes de esta semana, el Pontífice ha descansado bien durante la noche y su estado es estable, sin fiebre y sin necesidad de ventilación mecánica. Aunque su cuadro clínico sigue siendo complejo y el pronóstico reservado, estas noticias brindan esperanza a millones de fieles que oran por su pronta recuperación.
La comunidad internacional continúa atenta a la evolución de su sa -
lud. Se espera que, en los próximos días, los médicos proporcionen más detalles sobre su recuperación y el tiempo estimado de hospitalización. Mientras tanto, el Papa Francisco sigue recibiendo mensajes de apoyo y oraciones de líderes religiosos y fieles de todo el mundo.
Nos leemos la próxima semana y recuerda luchar, luchar siempre, pero siempre luchar desde espacios más informados que construyen realidades menos desiguales y más inclusivas.


J orge r ocha
Finalmente, el gobierno de Estados Unidos impondrá aranceles del 25% a México y Canadá. Desde la narrativa del presidente de aquel país, Donald Trump, su nación ha sido “maltratada” por sus socios comerciales y es hora de rectificar esta situación. Las razones que el primer mandatario estadounidense esgrime para este comportamiento son fundamentalmente dos: que los acuerdos económicos con estos dos países han resultado desventajosos para ellos y que la seguridad nacional de los Estados Unidos está en riesgo por la actuación impune de los grupos de la delincuencia organizada mexicanos. Estos dos asuntos han estado en la base
de sus argumentos, desde la campaña presidencial, y ahora como presidente de Estados Unidos.
La estrategia que el republicano ha usado para “hacer estas correcciones” es a través de la imposición de aranceles a México, Canadá y otros países como China. Al cerrar el año 2024, los datos que el INEGI reporta es que las exportaciones no petroleras de México se concentraron en los Estados Unidos, ya que representan el 84% de las mismas, dicho de otra manera, las exportaciones no petroleras de México hacia otros países que no sean nuestros vecinos del Norte sólo representan el 16% de esta actividad. Este proceso que ha sido muy rentable en los últimos años ahora está en riesgo por la imposición de aranceles.


La implementación de estos impuestos a los productos mexicanos que llegan al mercado estadounidense tiene tres efectos principales: el primero es que se encarece el precio de los productos de origen mexicano, con lo cual pierden competitividad frente a otros exportadores o frente a los productores locales estadounidenses. La segunda es que esta política inhibe la instalación de empresas que busquen producir en México y desde aquí exportar a los Estados Unidos, con lo que se puede generar una contracción de la inversión productiva en México. La tercera es que se puede afectar la economía de muchos hogares en Estados Unidos al tener un efecto inflacionario auto-impuesto, por el encarecimiento de los productos mexicanos y canadienses que se consumen allá, ya sea como mercancía final o como insumo para otros productos. Sólo para el caso de nuestro país, hay que recordar que las importaciones que hace Estados Unidos de productos mexicanos, es alrededor del 16% de su comercio global y por ello hoy México es el principal socio comercial de los Estados Unidos.
Esta fuerte interdependencia entre los dos países ha provocado resistencias de México y de estadounidenses a estos aranceles. El gobierno de Claudia Sheinbaum ha tratado de realizar accio-
nes que muestren interés y cooperación sobre las demandas del gobierno de Donald Trump, una de ellas fue la movilización de miles de efectivos de la Guardia Nacional a la frontera norte para contener migrantes y la otra fue la extradición de 29 personas presas en México a las cuáles Estados Unidos reclama por delitos cometidos en su país. Entre los reos más conocidos están Rafael Caro Quintero, fundador del Cártel de Guadalajara; y Miguel Ángel Treviño Morales, alias “El Z-40”, que fue el principal líder de los Zetas.
Ahora sabemos el tipo de aranceles que se implementarán y los efectos que pueden provocar, pero se antoja que durante cuatro años el gobierno de México será presa de estos amagues y amenazas. Frente a ello la administración de Claudia Sheinbaum deberá hacer un trabajo muy intenso de diplomacia con aquel país, además será muy importante ampliar los horizontes en los destinos de las exportaciones no petroleras y esto aparejado a una fuerte inversión en desarrollo científico y tecnológico. La agenda migratoria estará en vilo durante este tiempo y nuestro país deberá de contar con políticas robustas para acoger a personas deportadas, pero también generar programas y proyectos que inhiban la migración.
Sin duda alguna que el escenario no estará fácil para los próximos cuatro años. Habrá que esperar qué sucede, pero por lo pronto las Bolsas de Valores y el peso ya tuvieron un primer impacto sobre este evento que sin duda tensará las relaciones de México y Estados Unidos.
Post Data. La Cámara de Senadores aprobó las reformas que impulsó la presidenta Claudia Sheinbaum sobre la no-reelección y contra el nepotismo, sin embargo, las dos entrarán en vigor hasta el año 2030. Algunos senadores se opusieron a legislar contra el nepotismo a partir del año 2027 porque hay hermanos y padres “incómodos” que quieren suceder a sus parientes en sus cargos. Esperemos que la Cámara de Diputados les componga la tarea y no permitan que esto suceda.
Académico del ITESO Correo electrónico: jerqmex@hotmail.com





Un espacio digno y especial para el descanso eterno Nichos disponibles en el














Información 3314707921, o visítanos en el Arzobispado de Guadalajara. Alfredo R. Plasencia 995, Chapultepec Country.




















Durante su mensaje de Cuaresma, el Cardenal exhortó al presbiterio a alentar a los fieles con la esperanza del Año Jubilar para que todos luchemos por enmendar y mejorar nuestra vida.
S onia G abriela C eja r amírez
El miércoles 26 de febrero, el Cardenal José Francisco Robles Ortega, Arzobispo de Guadalajara, se reunió con su presbiterio para darles su tradicional mensaje de Cuaresma.
La cita fue en el Seminario Menor y la reunión inició con la oración frente al Santísimo. Posteriormente, durante su alocución, el señor Cardenal dijo a los presentes: “Es un gozo vernos así reunidos en la presencia del Señor, del que nos miró con amor, del Señor que nos eligió, que nos participó de su Espíritu para hacernos presencia viva suya en medio de su pueblo. No debemos olvidar esta realidad en nuestra vida”.
Añadió que la Cuaresma es una invitación a la conversión personal, pero también, en el caso de los sacerdotes, “no debemos olvidar que junto con nosotros camina el pueblo de Dios. De tal manera que, al iniciar este tiempo, sí debemos revisarnos y debemos responder en lo personal, en lo particular, pero también debemos de pensar en el pueblo que se nos ha confiado”.
El señor Cardenal invitó a los Sacerdotes a reflexionar centrándose en el mensaje de Cuaresma del Papa Francisco que lleva como título “Juntos caminemos en la esperanza”.
Explicó que el Papa integra el Año Jubilar y la sinodalidad como ejes centrales de su mensaje. “Enfatiza que la Iglesia es una comunidad sinodal y nos invita
a reflexionar sobre cómo vivimos esta realidad en lo personal y en lo eclesial”.
“El Papa desarrolla su mensaje en tres puntos clave. Primero, Caminemos, destacando la condición de peregrinos en la vida. Inspirado en el Éxodo, nos exhorta a tomar conciencia de que el camino es difícil, pero orientado hacia la libertad. Relaciona esta realidad con la situación de los migrantes, llamándonos a la conversión y a reflexionar sobre nuestra propia peregrinación: ¿Estamos avanzando o paralizados por el miedo y la comodidad?”
“Segundo, Juntos, subrayando la importancia de la sinodalidad”. Nos incita a caminar codo a codo, sin envidia ni hipocresía, incluyendo a todos sin excluir a nadie. Invita a revisar nuestra actitud en la comunidad, evitando el clericalismo y fomentando la unidad”.

“Tercero, En la esperanza, conectando con el Año Jubilar. Nos recuerda que la esperanza cristiana se fundamenta en la resurrección de Cristo y en la certeza del amor y la misericordia de Dios. Nos motiva a preguntarnos si confiamos realmente en el perdón divino y si vivimos con una esperanza activa que impulsa el compromiso por la justicia y la fraternidad”.
“Así -explicó el señor Cardenal- el Papa nos anima a caminar juntos, con fe y esperanza en este tiempo de Cuaresma”.
ACOGER Y ESCUCHAR A TODOS
Posteriormente, el Cardenal Robles se refirió a la buena respuesta que ha habido en nuestra Diócesis con respecto al Año Jubilar y pidió a los Sacerdotes escuchar con misericordia a los fieles, aún a quienes por su situación de vida no pueden gozar de las gracias del Jubileo, pero que sí pueden recibir un mensaje de aliento, de esperanza y consuelo. Finalmente, hizo a los sacerdotes algunas recomendaciones para mejorar su vida personal y su ministerio.




H ÉCTOR Q UINTERO L ÓPEZ
Comienza el periodo cuaresmal y con él, se retoma una de las celebraciones virreinales que más auge tuvo en su tiempo: Los Viernes en honor a Jesús Divino Preso. Si bien la devoción se mantiene vigente en los templos del centro de Guadalajara, esta tradición de honrar la Pasión de Cristo, por medio de estas imágenes, se mantuvo viva en los monasterios de Jesús María con las religiosas Dominicas y en el templo de la Inmaculada con las hermanas Capuchinas.
Desde el año 2023, uniendo esfuerzos entre los capellanes del centro encargados de los templos que correspondían a los demás monasterios que ya no cuentan con la presencia de religiosas, y en los antes mencionados que aún perviven, se retomó la celebración cuaresmal de ir viernes con viernes turnándose la festividad con triduo previo, siguiendo el orden tradicional: el primer viernes en Santa Mónica, el segundo en Jesús María, el tercero en Santa Teresa, el cuarto en Santa María de Gracia y el quinto en el templo de Capuchinas, aunque la ruta se extendía a la capilla de San Diego de Alcalá el sexto viernes que corresponde a la celebración de los Dolores y en la del beaterio de Santa Clara el domingo de Pasión.
DEVOCIÓN
ARRAIGADA
Las imágenes de Jesús Divino Preso son fáciles de encontrar en los templos del centro de la ciudad, el motivo, más que evidente: ante sus imágenes se encuentran personas orando, se observan ofrendas: ores, velas y exvotos. Todas ellas cuentan con un sinfín de devotos que a diario les visitan y pueden atestiguar los favores que han recibido por medio de Dios y todo esto no es gratuito, pues desde la fundación de algunos conventos o la creación de estas imágenes y sus cultos ancestrales, les rodea un aura milagrosa y por ello es que su devoción se mantiene viva.

su hechura. Se dice que la imagen fue encargada a un imaginero muy devoto que trabajaba en la imagen principalmente los días viernes, en los que además ayunaba, oraba y en este ambiente de recogimiento fue dando forma a su cuerpo, su rostro y al paso del tiempo le vio terminado; en medio de la contemplación de su obra, la imagen cobró vida un instante y volviéndose hacia su autor exclamó: “¿Dónde me viste, que tan bien me hiciste?”, siendo esta, la dádiva que Nuestro Señor le hizo por su entregada vocación escultórica.
El Corredor Cultural Fray Antonio Alcalde se ha sumado a esta celebración en honor al Divino Preso con una nueva ruta de templos, en los que, en punto de las 6 de la tarde se podrá meditar el Vía Crucis, siguiendo este orden: el primer viernes en San Francisco de Asís, el segundo en el Santuario de Guadalupe, el tercero en el Sagrario Metropolitano, el cuarto en el Santuario de San José de Gracia y el quinto en la Parroquia de Nuestra Señora del Sagrario, teniéndose también esta veneración los días jueves a las 8:00 horas en el templo de Nuestra Señora del Pilar.
Si bien, no se sabe cuál festividad era la más concurrida de la época novogalaica, una de las imágenes que ha mantenido acendrada devoción es el Divino Preso del templo de Jesús María, al cual acompaña una piadosa leyenda sobre
CAMINEMOS JUNTOS EN LA ESPERANZA
Con la invitación que el Santo Padre Francisco nos hace en su mensaje cuaresmal, aprovechando este tiempo de gracia por el Jubileo que tiene por lema “Peregrinos de esperanza”, como iglesia hacemos este caminar juntos hacia la Pascua, viviendo en esta cuaresma un tiempo de conversión a través de estas celebraciones en honor a Jesús Divino Preso.

Más información sobre horarios y cultos en la página de Facebook: https://www.facebook.com/share/1C2GiuP4VJ/?mibextid=wwXIfr

Q UETZALI C ÁRDENAS
La Universidad del Valle de Atemajac (UNIVA), institución católica comprometida con la formación integral de los estudiantes, presentó su informe de actividades 2024 bajo el lema: Desarrollo con visión de futuro. En este documento, el rector de la casa de estudios, el Pbro. Lic. Francisco Ramírez Yáñez, destacó los avances y logros alcanzados por la institución como el fortalecimiento de la calidad educativa mediante la acreditación de programas académicos, el crecimiento de la investigación y la vinculación con sectores productivos y sociales.
Además, la implementación de tecnologías innovadoras para los procesos de enseñanza-aprendizaje, el impulso a la internacionalización a través de convenios y alianzas estratégicas con organismos e instituciones de alto prestigio, y el rme compromiso con la responsabilidad social universitaria, re ejado en diversas iniciativas de impacto comunitario.
Ante estudiantes, directivos e invitados especiales, el rector recordó la misión de la institución y el compromiso que existe con los estudiantes.
“Los estudiantes de la UNIVA, al igual que la comunidad en general, deben sentir y saber que forman parte de un entorno educativo comprometido con acompañarlos en su formación profesional, valorando y respetando lo que son, mientras potencia aquello que están llamados a ser. De esta manera, la UNIVA busca formar profesionales, líderes de transformación social en la línea con su lema, saber más para ser más.”, dijo.
UNIVERSIDAD COMPROMETIDA
El rector, habló de los compromisos establecidos para este 2025, año en el que se cerrará el Plan Institucional de Desa-


L a comunidad del Sistema UNIVA está conformada por 13 mil 153 personas, de las cuales, 11 mil 144 son estudiantes y dos mil nueve colaboradores
rrollo 2021-2025 de la UNIVA. Por ende, una de las prioridades, será elaborar un plan estratégico para los próximos años. A partir de los resultados obtenidos, donde se enfoque en dar prioridad a los siguientes procesos y funciones. Destacó que se cuidará la calidad del servicio. “La UNIVA rea rma su compromiso de ser una institución donde la persona sea el centro de su proyecto educativo, asegurando la satisfacción de sus usuarios mediante procesos y procedimientos optimizados”.
Añadió que se fortalecerá la experiencia universitaria.
Desde la atracción, el acompañamiento y la delización de los estudiantes, hasta la consolidación de la comunidad de alumnos, la universidad trabajará para enriquecer la vida académica y profesional de su comunidad.
En lo que se re ere a la cultura organizacional, precisó que se impulsará la homologación y optimización de procesos administrativos, promoviendo el bienestar del talento humano y un liderazgo acorde con los propósitos institucionales.
Finalmente, en sostenibilidad del sistema universitario, cada unidad administrativa cuidará su equilibrio nanciero y la optimización de recursos para garantizar la continuidad de un servicio educativo de calidad.
Como respuesta a los resultados expuestos, el Lic. Víctor Flores Arroyo, vicepresidente del ISAO, A.C., agradeció a la comunidad universitaria por los logros emprendidos en el 2024.
“Mi felicitación en especial a usted, Padre Francisco, por su preocupación y, sobre todo, por su ocupación en llevar esta comunidad universitaria a un buen camino, por su legado y trascendencia, que muchos sigamos beneficiándonos de su servicio” expuso.
Añadió que uno de los retos más importantes para este año, es el de reforzar el valor de la honestidad que promueva la integridad y la coherencia en todas las áreas y proyectos de la comunidad universitaria.
Durante la presentación del informe de actividades estuvieron presentes, autoridades académicas del Sistema UNIVA, directoras y directores de sus campus. Además, asistieron invitados del ámbito educativo, gubernamental y empresarial, entre ellos, Juan Carlos Flores Miramontes, secretario de Educación del Estado de Jalisco; Merlyn Schultz, public a airs o cer del Consulado General de los Estados Unidos en Guadalajara; Luis Gustavo Padilla Montes, rector del Centro Universitario de Ciencias Económico Administrativas de la Universidad de Guadalajara y Jorge Francisco Rocha Orozco, director general del Tecnológico de Monterrey, campus Guadalajara.
Su participación rea rmó el compromiso de la universidad con el fortalecimiento de alianzas estratégicas y el impulso de proyectos de desarrollo conjunto.












S ergio e S trada
Derivado del pasado Sínodo de la sinodalidad, se llevó a cabo el Primer Encuentro de Responsables y Coordinadores de Comunidades de Misioneros Digitales de América Latina y El Caribe: “Conecta2”.
En el encuentro estuvieron presentes: Mons. Daniel Francisco Blanco, coordinador de comunicaciones del CELAM, Mons. Lucio Adrián Ruiz, Secretario del Dicasterio para las comunicaciones del Vaticano, el Padre José Juan Montalvo, miembro del Consejo de Comu nicación del Consejo Episcopal Latinoa mericano y del Caribe (CELAM) y José Manuel Urquidi González, participante en el Sínodo de la sinodalidad en la misión digital.
El evento tu vo lugar en las ins talaciones de la Obras Misionales Pontificias Episcopales de México, con el objetivo de fortalecer la unidad y la misión digital de las Iglesias, creando un espacio sinodal para compartir ideas y construir una red de misioneros digitales y representantes episcopales de Latinoamérica y el Caribe.

Iglesia, pero también acompañando a los misioneros digitales que han surgido por el Espíritu Santo, reconocieron los Obispos. Se busca cómo se puede instituir la Pastoral Digital en la parroquia, en las diócesis, en la Conferencia Episcopal, para acompañar a los que evangelizan en las redes sociales de esta situación surgen varias preguntas: ¿cómo se acompaña a los equipos de redes sociales de una Parroquia?, ¿qué formación se les da?, ¿qué acompañamientos de espiritualidad se les ofrece?, por mencionar algunas. Por ello se reflexionó para estructurarlas e instituirla en la pastoral orgánica de la Iglesia. Con estas actividades, se busca crear y promover la “misión digital”, como una nueva página de comunicación eclesial a través de una red de comunicación entre los misioneros digitales de las Conferencias Episcopales de América Latina y el Caribe, mencionaron los ponentes.


Es necesario que los participantes se conozcan, mediten y reflexionen sobre la misión digital, que es un nuevo carisma de la Iglesia, y respondamos a este llamado, tanto como institución como

“Con estos eventos también se acompaña a los hermanos que se dedican a la misión digital dentro del Continente, donde la mayoría son jóvenes. Se ve esta necesidad de reunir a los que se están ocupando de estas misiones digitales desde el CELAM, junto con el Dicasterio de Comunicación y la posibilidad de
darles cursos para que sus trabajos sean más cercanos a la Iglesia”, subrayó Mons. Lucio Adrián Ruiz, Secretario del Dicasterio para la comunicación.
Destacó la continuidad con la tradición misionera y la urgencia ante las demandas existenciales de la cultura contemporánea: “Muchos buscan una razón para vivir sin saber que anhelan a Cristo. No se trata de inventar estra-
https://academy.arquimediosgdl.org.mx


tegias sino de seguir el mandato de ser una Iglesia en salida”. Como parte de la Iglesia se continúa como una nueva pagina en la misión histórica en la Iglesia, “hoy se responde con la cultura digital a través de las redes sociales para hacer presente el Evangelio. Es hacernos entender por esta cultura, la misión digital que nos toca a toda la Iglesia descubrir cómo hacerlo”, agregó.

















































Con una misa de acción de gracias, celebrada por el coordinador de la Sección Diocesana de Evangelización y Catequesis de la Arquidiócesis de Guadalajara (SEDEC), Mons. Manuel González Villaseñor, el pasado 21 de febrero se llevó a cabo el acto académico de la generación 2021-2024 de la Licenciatura de Catequética, impartida por el (ISCA) integrada por 32 estudiantes.
(…) para ser discípulos y apóstoles tenemos que renunciar a nosotros mismos para seguir a Jesús, implica en ocasiones sacrificios, pero cuando ese sacrificio o renuncia se hace por amor a Jesús, las cosas cambian, la vida mejora”, expresó.
¿Qué es la catequética?
La catequética o ciencia catequética, es la disciplina que se ocupa de la catequesis, en cuanto proceso y en cuanto acto, en el contexto de la praxis pastoral de la Iglesia
En la reflexión de la homilía, el Obispo Manuel González, explicó a los graduados que, en la catequética, a pesar de las dificultades, es importante continuar con la misión de evangelizar, aprendiendo del Maestro que los continuará instruyendo sobre las dificultades que implica seguirle y servirle.
“Nosotros desde que nacimos hemos sido discípulos de nuestros padres, posteriormente de nuestros maestros en las escuelas, ahora discípulos de la carrera
Monseñor Manuel, agregó que un verdadero profesionista no solamente se limita a ejercer lo que aprendió, sino que, en ese ejercicio, tiene que transmitir a Jesús, por ello, invitó a los nuevos egresados del Instituto Superior de Catequética (ISCA) a seguir el ejemplo de Nuestro Padre Dios.
En la celebración Eucarística concelebraron el Pbro. Mtro. Juan Carlos Mayorga Enríquez, Director del ISCA; y el Pbro. Lic. Javier Eduardo Acosta Águila, Subdirector de ISCA.
ACTO ACADÉMICO
Al concluir la celebración Eucarística, se llevó a cabo el acto académico, donde los presentes en el presídium, Mons.

Manuel González; el director de ISCA; el subdirector ISCA; Pbro. José Manuel Juan Pedro Delgado, Secretario Ejecutivo de SEDEC; y los padrinos de generación 2021-A y 2021-B el Mtro. Roberto Zermeño Delgadillo y la Mtra. Gloria Raquel Torres Ayala, madrina de la generación 2021-C, hicieron la entrega de títulos como Licenciados en Catequética a los alumnos presentes.
El Pbro. Juan Carlos Mayorga, felicitó a los profesores del Instituto de Catequética y a los recién egresados, al ver los frutos cosechados del esfuerzo de las personas que han colaborado en esta institución e hicieron posible que esta generación pueda prestar un servicio más solidificado en la evangelización en las diversas comunidades y de los diversos países donde han sido llamados a servir.
“Los invitamos también a seguir orando por estos catequistas y por quienes nos ha encomendado la misión de servir y contribuir en la formación profesional de los catequistas de la Iglesia”, agregó.
AGRADECIDOS
A nombre de los egresados de la generación 2021-2024, la alumna Monserrat Cervantes Palacios compartió una
breve reflexión sobre el acontecimiento formativo profesional que se celebraba y concluía, destacó:
“Hago énfasis en el eslogan de la licenciatura: formar para transformar; con agrado, cada uno de los graduados podemos dar fe de qué es una realidad, gracias a la vinculación de los conocimientos y saberes adquiridos en cada una de las materias cursadas, así como los aportes de los profesores que nos acompañaron en este proceso, nos transformamos en mejores personas con nuevas capacidades, conocimientos y habilidades”.
Finalmente, Mons. Manuel González, se dirigió a los licenciados en catequética, diciéndoles que ahora que son profesionistas, no significa que el aprender haya terminado, sino que hay que seguirse formando y aprendiendo.
“Ahora hay que seguir enfrentando los retos que la sociedad nos propone, seguir aprendiendo esas maneras de comunicarnos con los demás; y si lo hacen con la unidad y el amor a Dios, al seguirse preparando, estoy seguro que entonces sí, cuando lleguemos a la vida eterna van a llegar con una estola espiritual y una gran constancia donde el Señor les diga o nos diga: cumpliste con lo que Dios te pidió.”


R AMIRO E SCOTO R ATKOVICH
Las últimas tres semanas han sido de constante información respecto a la salud que guarda el Papa Francisco en Roma, algunas versadas en desmentir lo publicado por in uencers que, sin escrúpulos y sin conocer del tema, o incluso sin estar en el lugar de la noticia, aseguraban la muerte del pontí ce; todo, por ganar seguidores y monetizar el contenido.
Los medios locales de Italia, nunca publicaron nada de lo que en occidente se aseguraba: ni una renuncia, ni la convocatoria a un consistorio o un cónclave, aquí, desde donde me encuentro redactando esta nota, -en El Vaticano-, los medios acreditados nos hemos dado a la tarea de informar realmente lo que sucede mediante los cortes informativos a las 8:00 de la mañana y a las 6:45 de la tarde, mismos que emite la o cina de prensa de la Santa Sede, así como los médicos que atienden al Papa Francisco en el piso 10 del policlínico Gemelli.

El Santo Padre se recupera de una Polineumonía y Bronquitis que, a sus 88 años y con un pulmón y medio que le funciona desde que tenía 18 años, es un padecimiento difícil y riesgoso. Todo habría comenzado justo semanas atrás donde en varios eventos y audiencias, ofreció disculpas por no terminar de leer los discursos, la tos, la gripe, pero, sobre todo, el trabajo que se negaba a dejar para descansar le cobró la factura y lo envió al hospital a que la medicina hiciera lo propio. En Roma, la temperatura tampoco ayuda mucho; en un solo día, se pueden experimentar las 4 estaciones del año y para cualquiera eso suele pegar en las vías respiratorias si no está acostumbrado al clima que, en especial, arremete en esta época.
ESPERAN SU REGRESO
El Regreso del Papa a sus actividades cotidianas tendrá por supuesto variantes, serán sin duda “candados” a lo que anteriormente hacia con regularidad, a la espera de lo que al nal determinen los médicos, así como su propia condición, seguramente le veremos en episodios asistido por oxigenación auxiliar, aunque por el Año Jubilar no se tiene planeado ningún viaje, éstos tendrán que posponerse o evitarse, así como tendrá que permanecer en climas establecidos para su propia protección.


Santa Marta, el lugar donde reside el Papa Francisco desde el inicio de su ponti cado, también se estará preparando para su regreso, extrao cialmente sabemos que en el interior del edi cio comenzarán adecuaciones para hacer una especia de sala de urgencias en caso de que se requiera y poder atender una crisis en el momento que se presente y poder estabilizarlo antes de acudir al Gemelli, que se encuentra a 30 minutos de la Santa Sede, y aunque sabemos que la persona que acompaña y lo atiende de primera instancia es un enfermero, las indicaciones seguramente tendrán que incluir de tiempo completo a un médico especialista en vías respiratorias.
COBERTURA MEDIATICA
Más de 450 periodistas se acreditaron a la o cina de prensa del Vaticano para cubrir el estado de salud de Francisco, la mayoría lo hizo en preparación de una fatalidad y lo que sigue tras de ella, pero los demás estamos para documentar el proceso de la atención de quien actualmente dirige la Iglesia Católica en el mundo y establece como mecanismo de comunicación, la verdad documentada.

El Cardenal Pietro Parolín, Secretario de Estado Vaticano lo dijo a un periódico italiano: “Hoy se reza porque el Papa se cure y se Reza para que regrese al ministerio petrino”… nada que ver con quien a base de las fake news y en la comodidad de un escritorio y un ordenador o un celular se dedica a viralizar el estado de salud del líder de la Iglesia Católica mundial. “El bien Vencerá en el mundo, aunque el mal haga más ruido” (Papa Benedicto XVI)



P bro . L uis b ecerra
Hace unas semanas, para ser exactos el pasado 15 y 16 de febrero, se llevó a cabo el XV Congreso para personas separadas, divorciadas, divorciadas vueltas a casar y matrimonios en crisis ARDERE CORDIS, durante el cual se desarrollaron diferentes conferencias, y se brindaron asesorías personalizadas de parte del Tribunal Eclesiástico, familiólogos, tanatólogos y de la dirección espiritual por seminaristas y sacerdotes.
La parroquia de Nuestra Señora del Sagrario, atiende una pastoral especial para personas separadas, divorciadas y divorciadas vueltas a casar a través del grupo “Esperanza”, que realiza algunos retiros de fin de semana durante el año y después da seguimiento cada semana a sus participantes. El grupo se formó hace más de 25 años atendiendo y acompañando a personas en esta situación, acercándolas a la Iglesia para que puedan llevar una vida de fe y testimonio.
El lema fue: “La Esperanza no defrauda”, en sintonía con el Año Jubilar que se vive en toda la Iglesia, y en el contexto de vivir la Misión de la Misericordia, asistiendo a los más alejados y a las periferias existenciales, tomando en cuenta que algunas personas que viven esta realidad, pueden en algún momento sentirse excluidos por algunos miembros de la Iglesia.
La temática fue sobre situaciones que viven concretamente las personas que están en una separación o divorcio, como:” los hijos en el divorcio”, o “tus hijos, mis hijos y los nuestros”, “mi nueva pareja”, “la realidad de los divorciados en el ambiente social”, también se abordaron temas como la dignidad de la persona divorciada.
Las charlas estuvieron a cargo de los Sacerdotes José Luis González Santoscoy, Octavio Ramírez, José Luis Becerra, David Silva, Daniel Guadalupe Jiménez, Luis Heliodoro Salcedo, Israel Cervantes y de los especialistas en formación humana Enrique Pacheco y Sendy Jiménez.
Con una Hora Santa realizada a cielo abierto y con la celebración de la Sagrada Eucaristía, los asistentes se sintieron acogidos, al darse cuenta que no son rechazados por la Iglesia, sino que, como Madre y Maestra, acoge y orienta a sus hijos en toda situación.










P bro . J. J esús s uárez A rell A no
El tiempo de CUARESMA es un periodo de conversión para mejorar:
• Nuestra relación con Dios, meditando, acercándonos a los sacramentos y comulgando con sus valores y proyectos.
• Nuestras relaciones humanas-fraternas, realizando obras de misericordia, compartiendo con los desfavorecidos, reconciliándonos con quienes ofendimos.
• Nuestra relación con nosotros mismos recuperando nuestro equilibrio emocional y mortificándonos con abstinencias y ayunos.
Para acompañar este camino, aquí ofreceremos un tema semanal basado en alguna/s de las lecturas de los domingos. Comencemos con el primero:
¿CÓMO VENCER LAS TENTACIONES?
¿Confío en Dios o busco sensualidad, admiración y control?
¿QUÉ NOS DICE DIOS
HOY EN SU EVANGELIO?
Lucas 4, 1-13: Jesús es invitado por el diablo a que sea inmoderado, a abusar de su poder y a manipular la voluntad Dios a su conveniencia. Al vencer nos muestra su congruencia y libertad.


REFLEXIONEMOS:
Hoy vemos a Jesús venciendo las tentaciones de realizar su misión por vías fáciles, inmediatas y centradas en sí mismo. Esas mismas tentaciones las tenemos nosotros también:
• La de permitir que los bienes de consumo nos controlen. Jesús rechazó esta fascinación y nos invita a que tengamos hambre de Dios.
• La de crear nuestros propios ídolos y de colocarnos al centro del universo. Jesús afirmó que sólo debemos darle culto a Dios.
• La de impresionar y de controlar a los demás y a Dios. Jesús confió su vida en las manos de Dios y nos invita a convencernos de que nunca seremos decepcionados por él.
Cuándo se me presentan estas tentaciones, ¿cómo las venzo? Al pensar en mi misión en la vida, ¿dejo con confianza que sea Dios quien me guíe?
Aclaremos que, aunque Jesús realizó algunos milagros, nunca lo hizo para impresionar o controlar a nadie ni para obtener beneficios personales. Pedía discreción y, luego, se ocultaba para que no lo proclamasen rey ni lo confundieran con un simple “mago”.
Al parecer, el diablo aprovecha un momento de vulnerabilidad de Jesús, después de cuarenta días con hambre y en soledad. Así, cuando tenemos necesidades insatisfechas somos más frágiles y el “diablo” aprovecha para tentarnos. De aquí podemos inferir varias tareas:
1. Identificar áreas de nuestra vida subdesarrolladas para atenderlas y sanarlas paulatinamente. ¿Descubro algunas de mis necesidades insatisfechas que me dejan vulnerable?
2. Dedicar momentos para, como Jesús, “mortificar” nuestro cuerpo y ayunar para dominar nuestras pasiones; para compartir nuestros bienes y vencer nuestro egoísmo; y para hablar con Dios de lo que requerimos para encontrar la mejor manera de cumplir nuestra misión… ¿Qué puedo hacer para fortalecerme desde la fe y resistir las tentaciones?
Finalmente, recordemos que la palabra de Dios es la fuente de nuestra fortaleza, en ella encontraremos respuestas a los desafíos de la vida. Así nos lo demostró Jesús. ¿Me esfuerzo en conocer y amar la Palabra y me capacito para comprenderla y vivirla?
TE PROPONEMOS LOS SIGUIENTES EJERCICIOS PARA ESTA SEMANA:
1. El ayuno purifica, fortalece la voluntad, abre a la acción de Dios y vence tentaciones. Compara cuando eres consciente de cuánto y qué comes y bebes con las veces en que te descontrolas. ¿Descubro qué tan controlado o descontrolado estoy en mi vida? ¿Cómo sin saborear? ¿Qué otras actividades realizo para satisfacerme, pero sin disfrutarlas e, incluso, agrediéndome o agrediendo a otros? ¿Descubro en mí alguna adicción que me aparta del proyecto de Dios?
2. Descubre y escribe cuáles son tus tentaciones más fuertes de impresionar, controlar y manipular a otros -y a Dios- en estos días.
3. En la medida en que vayas respondiendo los ejercicios anteriores, ve dialogando confiadamente con el Señor sobre lo que vas descubriendo.



F abián a costa R ico / U ni V a
l neoconservadurismo parece resurgir con fuerza tras años de dominio progresista. Ejemplo de ello es la victoria de Donald Trump, que, al ganar la presidencia de Estados Unidos, dejó claro que algo de su ideología impactará globalmente. Su influencia ya ha contribuido a la dimisión del progresista primer ministro canadiense Justin Trudeau y a que Bob Iger, CEO de Disney, pusiera fin al adoctrinamiento woke en las producciones de la compañía.
En México, aunque la presidencia de Claudia Sheinbaum garantiza continuidad a la Cuarta Transformación (4T), la relación entre el gobierno y los grandes empresarios suele ser tensa. Andrés Manuel López Obrador buscó limitar el poder de los ricos y acabar con la plutocracia, lo que lo llevó a rivalizar con magnates como Ricardo Salinas Pliego, dueño de TV Azteca y Grupo Elektra.
Salinas Pliego, sin llegar al nivel mediático de Elon Musk, ha dejado claro su neoconservadurismo. En redes sociales ha protagonizado polémicas, como su enfrentamiento con la exsenadora Citlalli Hernández, donde fue acusado de gordofobia y misoginia. También se solidarizó con un motociclista que intentó atravesar una marcha feminista y terminó enfrentándose al contingente. Incluso le ofreció una nueva moto de su marca Itálica tras el incidente.

boradores que salen en pantalla, quiero decirles que ser ‘diferentes’ en un mundo lleno de insensatez… es valentía. No caigan en tratar de encajar y ser normales”.
DEFENDIENDO SU POSTURA
En programas como Ventaneando y Hechos, el lenguaje inclusivo ha sido vetado. El empresario incluso ironizó sobre el tema en una carta difundida en redes:
El lenguaje woke, entendido como inclusivo y no discriminatorio, busca visibilizar a todos independientemente de su género, raza o cultura. Frases como “chiquillos y chiquillas”, usadas por el expresidente Vicente Fox, o el famoso “todes” para referirse a géneros no binarios son ejemplos claros. Aunque sus defensores intentan normalizarlo, su aceptación sigue siendo limitada.
Recientemente, el empresario volvió a ser noticia por criticar el lenguaje woke y prohibir su uso en las producciones de TV Azteca. En su cuenta de X declaró: “A mis cola-

“Carta/Carto a mis colaboradoras/colaboradores: Los televidentes y televidentas, a través del dueño y la dueña de TV Azteca/Azteco, les solicitan a los productores y productoras de noticias y noticios que den instrucciones a sus presentadores y presentadoras de pantalla y pantallo...”
QUE DEJEN DE USAR DE INMEDIATO EL ‘LENGUAJE WOKE’.”
La publicación desató reacciones divididas en la red X, una verdadera Torre de Babel moderna. Mientras algunos lo aplaudieron, otros, especialmente los sectores progresistas, lo criticaron. A estos últimos, Salinas Pliego respondió categóricamente:
“Ayer vi a varios ‘progresistas’ ofendidos porque en mi empresa yo establezco las reglas. No estoy en contra de la libertad de cada quien para percibirse como
desee; solo pido, por favor, que también se respete mi libertad de percibir a las personas como realmente son y listo.” Como cierre, el empresario reflexionó: “Lo políticamente correcto está destruyendo el sentido común y distorsionando la realidad. No se ofendan, cálmense y comiencen por aceptarse a ustedes mismos tal como son; luego, si quieren, luchen para que los demás los acepten como les gustaría ser.”
Salinas Pliego, firme en su postura de “Mi empresa, mi dinero, mis reglas”, refuerza su identidad como uno de los principales representantes del neoconservadurismo en México.



S ergio P adilla M oreno
Justo en el Año Jubilar, que como Iglesia reactivamos la fuerza de la esperanza, la realidad del mundo parece que apunta más bien hacia la desesperanza, pues valores tan esenciales como la verdad y la libertad están seriamente atacados, paradójicamente, en nombre de ciertos modos de entender la verdad y la libertad. Es tiempo de formarnos en el discernimiento, entendido en el contexto de la espiritualidad, como la capacidad de percibir, interpretar y elegir con claridad lo que es verdadero, bueno y alineado con un propósito superior o con la voluntad divina. Implica un proceso de reflexión profunda, guiado por
la intuición, la conciencia y la sabiduría del Evangelio. El discernimiento hoy en día es algo urgente, pues hace un siglo condiciones parecidas a la actuales llevaron al mundo a momentos oscuros y trágicos. Propongo tres temas a discernir. Muchas personas aplauden la decisión del presidente Donald Trump de cancelar la llamada “ideología woke”, así como, desarticular y poner en entredicho la llamada “Agenda 2030”, especialmente la cuestión de la llamada ideología de género y el tema del cambio climático que él considera una falsedad. Y quizá aplauden porque no comparten esos postulados, por la razón que sea, pero la falta de discernimiento y desarrollo de un sólido sentido crítico hace que no se tenga

claridad de los propios argumentos y que, por otra parte, no se vean los riesgos del pendulazo hacia esa otra agenda contraria que se promueve como oveja, pero que esconde su piel de lobo.
Otros aplauden y apoyan el control y censura de la información que circula en las diferentes redes y medios de comunicación en función de combatir las “fake news” que puedan “confundir” a la población.
Hoy este control es complejo por la penetración de las redes sociales, pero hay modo de hacerlo, tal como lo hacen regímenes totalitarios, pero también élites occidentales económicas y políticas de países “democráticos”, como pasa en la Alemania liberal de hoy, y como pasó en 1933 cuando los nazis quemaron públicamente los libros que consideraban “peligrosos” al régimen. Valdría la pena discernir la validez del postulado, atribuido erróneamente a Voltaire: “No estoy de acuerdo con lo que dices, pero defenderé hasta la muerte tu derecho a decirlo”, aunque ello implique, ni modo, escuchar o leer necedades.
Hay también quienes aplauden las estridencias del presidente argentino al proclamar una libertad radical, pero que apunta más hacia el “hacer y pensar lo que me da la gana”, y que le llevó al insultar al Papa Francisco y a toda persona que ve al mundo desde una perspectiva diferente. Se defiende una libertad
con sesgos ideológicos, pero desde una situación de privilegio y sin el menos contrapeso de la responsabilidad que va de la mano con ese valor.
Un discernimiento abierto a la voz del Espíritu activará la esperanza y nos llevará comprender que el mundo no es blanco o negro, pues entenderlo o situarse así, de manera tan radical, lo único que hará es perpetuar las sombras de un mundo cerrado que denunció el Papa Francisco en su encíclica Fratelli tutti.

padilla@iteso.mx

Alerta dictadura digitalAlemania cruza todos los limites contra la libertad de expresión. https://www.youtube. com/watch?v=VKydU3r-1t0

Desde el Corazón
QUERIDA LUPITA:
Me vine a los Estados Unidos a trabajar para sacar a mis hijos adelante. No pude traerlos conmigo hasta 4 años después, hoy tienen 8 y 9 años. Ellos resintieron mucho mi partida, pues primero nos dejó su padre y luego yo me fui, están muy groseros y desobedientes. Necesito saber cómo actuar.
HERMANA MÍA, PINA:

La situación que me planteas es cada vez más común, buscando lo mejor para nuestros hijos podemos herirlos sin querer. Recuerdo una frase que vi escrita en un consultorio de terapia psicológica: “Los padres de familia de hoy trabajan mucho para darles lo mejor a sus hijos, pero no están con ellos”. Y es que el mundo acelerado y consumista nos convence de vivir para producir, y en ocasiones quedamos engañados pensando que lo mejor es dar cosas a nuestros hijos, cuando lo que más necesitan es nuestro tiempo, presencia y convivencia. Los padres ausentes lastiman a sus hijos. Ellos necesitan sentirse valorados, protegidos y amados. Cuando se cubren estas necesidades generamos hijos seguros y confiados.
Las tendencias en educación actual nos llevan a dar importancia a las emociones de nuestros hijos, procurar entenderlos y dar espacio a sus sentimientos mostrando empatía y respeto, pero sin renunciar a mostrar la capacidad que tenemos todos de elegir nuestras respuestas. Esto es: dar lugar al sentimiento y validarlo, además, enseñar el dominio propio que nos permite elegir la respuesta más adecuada ante las circunstancias dadas.
“Educa a los niños y no tendrás que castigar a los hombres”. Pitágoras. Cuando se trata de educar a los hijos pidamos en primer término la ayuda de Dios, así que el primer paso será orar. Orar sinceramente por el bien de nuestros hijos y el nuestro propio, la oración eficaz siempre lleva a la acción asertiva.
Hablarles y modelar para ellos los valores esenciales: respeto, responsabilidad, generosidad, justicia, entre otros. Distinguir el bien del mal y reconocer los
10 marzo
Pbro. Jesús Maximino Álvarez Hernández
Pbro. Sergio Augusto Garduño Osorio
11 marzo
Pbro. Ricardo Durán Aguayo
Pbro. Gudberto Gamboa Melgarejo
Pbro. Juan Manuel Gutiérrez Acevedo
Pbro. Edgar Iván Preciado Mariscal
Pbro. Victoriano Chitala Cortés
12 marzo
Pbro. José Antonio Gutiérrez Castañeda
Pbro. Mario Alejandro Lozano García
Pbro. Gregorio Nuño Padilla
Pbro. Rubén Martín Plancarte López
Pbro. Juan Manuel Ruiz Aguilar
anti-valores, o las acciones que nos hacen daño a nosotros mismos y a los demás: faltas de respeto, irresponsabilidad, egoísmo, injusticia… Para nuestros hijos hemos de ser siempre un faro luminoso, un puerto seguro. Ellos deben saber que cuentan con nosotros para su bien, que tenemos palabras bondadosas y sabias para compartirles en todo momento. Pidamos a Dios la sabiduría que nos permita actuar conforme a sus designios.
Lupita Venegas/Psicóloga Facebook: lupitavenegasoficial

Padres que cumplen años
Pbro. José de Jesús Ruiz Reynoso
13 marzo
Pbro. Clemente Rodrigo Navel Cedeño
14 marzo
Pbro. Diego Francisco Cortés Martínez
Pbro. Gustavo Albino Placencia Robles
Pbro. Mauricio Velasco Vargas

15 marzo
Pbro. Luis Alfonso García Fuentes
Pbro. Heriberto Mayorga Enríquez
16 marzo
Pbro. Salvador Anguiano Hernández
Pbro. César Augusto Ronquillo Proaño
“Padre, ¿qué dice la Iglesia acerca
in vitro?”
UP bro . E duardo M ich E l F lor E s
na vez una señora me preguntó:
“Padre, ¿qué dice la Iglesia acerca de la fecundación in vitro?, porque mi esposo y yo no hemos podido embarazarnos y un médico nos propuso este método de fecundación, pero una amiga me dijo que ella tenía entendido que ese método de fecundación no estaba permitido por la Iglesia, pero como no estaba segura mejor quise venir a preguntar”, yo le respondí: “la Iglesia enseña que la fecundación in vitro (FIV) es moralmente ilícita, incluso en casos donde la intención es buena, como superar la infertilidad. Esta enseñanza se fundamenta en varios principios éticos y antropológicos, particularmente en la dignidad de la persona humana, la unidad del acto conyugal y la concepción del hijo como un don, no un derecho”.
1. Enseñanza de la Iglesia sobre la fecundación in vitro. El Magisterio ha abordado este tema en documentos como la instrucción Donum Vitae (1987) y Dignitas Personae (2008), elaborados por la Congregación para la Doctrina de la Fe. Estas enseñanzas destacan tres razones principales por las que la FIV es considerada inmoral:
• Disociación del acto conyugal: La procreación humana debe ser fruto del amor conyugal expresado en la unión íntima entre los esposos. La FIV separa la dimensión unitiva y procreativa del acto matrimonial, convirtiendo

la concepción en un proceso técnico realizado en laboratorio.
• Manipulación y descarte de embriones: En la práctica, la FIV suele implicar la creación de varios embriones, de los cuales algunos son implantados y otros descartados, congelados o utilizados en investigaciones, atentando contra la dignidad del ser humano desde la concepción.
• Instrumentalización de la vida humana: En la FIV, el hijo es producido mediante una intervención técnica, lo que puede implicar verlo como un objeto de deseo y no como un don gratuito de Dios.
2. ¿Existen casos en los que la FIV pueda ser moralmente lícita? No. La Iglesia no aprueba la FIV en ningún caso, ya que su inmoralidad no depende de la intención (el deseo de ser padres) ni de las circunstancias (como la infertilidad), sino de la naturaleza misma del procedimiento, que vulnera principios esenciales de la antropología cristiana.
Sin embargo, la Iglesia promueve el uso de métodos moralmente lícitos para ayudar a las parejas con dificultades de fertilidad, como la naprotecnología, que busca restaurar la fertilidad natural sin recurrir
a métodos artificiales que violen la ética cristiana.
3. ¿Existe un “derecho” a tener un hijo? Desde la perspectiva cristiana, el hijo nunca es un derecho sino un don. No existe un “derecho a un hijo” como si fuese un bien de consumo que alguien puede exigir o fabricar. Más bien, el hijo tiene derechos desde su concepción, entre ellos, el derecho a ser concebido mediante un acto de amor entre sus padres y a ser acogido como un regalo, no como un producto de una técnica.
Este principio se basa en la dignidad del niño como persona y en la verdad de la paternidad y maternidad como vocaciones abiertas a la Providencia divina, no como exigencias absolutas de los padres. La Iglesia invita a quienes sufren infertilidad a vivir su matrimonio en plenitud, considerando otras formas de paternidad y maternidad, como la adopción que respeta la dignidad del niño y la de los esposos.
En conclusión, la FIV no es moralmente aceptable desde la perspectiva católica, ya que disocia la procreación de la unión conyugal, pone en riesgo la dignidad de los embriones y contradice la visión cristiana del hijo como don.
Hasta la próxima semana, si Dios quiere.


P BRO . A DRIÁN R AMOS R UELAS
“Haz de mí un instrumento de tu paz” (San Francisco de Asís)
Asís, Italia, es un lugar encantador. En ese gran pueblo cercano a Roma se respira la santidad. Tiene un toque místico. Algunos dirían, “casi mágico”. Ubicada en la región de Umbría, esta población ofrece, además de la espiritualidad que es principal atractivo turístico, historia y gastronomía a los millones de peregrinos que acuden cada año. Grandes santos han coincidido en este lugar y en su encuentro con el Señor. Se recuerda al Obispo san Ru no, cuya catedral constituye una importante iglesia de Asís, Italia, y destaca en la historia de la orden franciscana. En esta iglesia San Francisco de Asís, Santa Clara y muchos de sus discípulos originales fueron bautizados.
1. SAN FRANCISCO DE ASÍS. El célebre Francisco atrae por su vida y ahora con sus restos mortales a miles de jóvenes de todo el mundo por su testimonio de conversión y amor a Cristo. El “Poverello”, hijo de Pedro Bernardone, comerciante en telas y de Picca, mujer de profunda fe, un buen día renunció a los bienes materiales y de familia para dedicarse por entero a ser juglar de Dios con un estilo de vida pobre y libre, a ejemplo de las aves que son alimentadas por la Providencia.
2. SANTA CLARA DE ASÍS. Bella doncella de familia acaudalada, siguió sus mismos pasos contra la voluntad de los suyos y aventajó en penitencia a su admirado Francisco. Con ella comienza la Orden de las Clarisas, uno de los Institutos de la Segunda Orden de San Francisco, fundadas en 1112.
3. SAN GABRIEL DE LA DOLOROSA. En esta bella ciudad nació San Gabriel de la Dolorosa (Francisco Possenti) El 1º de marzo de 1838, nació en el pueble-


cito de Asís. Era el undécimo de trece hermanos y quedó huérfano de madre a los cuatro años. Al igual que Francisco de Asís, dejó una vida prometedora y vana para seguir el camino de Cristo inspirado por la Virgen, Nuestra Señora de los Dolores. Todavía adolescente se en ló en la Congregación de la Pasión y pronto consumió ahí su vida. Ha sido declarado copatrón de la juventud católica en Italia.
4. BEATO CARLO ACUTIS. Desde 2019, los restos mortales del beato Carlo Acutis, próximo a ser canonizado, reposan en el Templo de Santa María la Mayor en Asís, mejor conocido como el Santuario del Despojo, donde Francisco renunció a todo derecho legítimo con su familia y trato con el mundo.

1 2 3
Un sagrario, una capilla, toda una ciudad pueden llegar a ser inspiradores de una vida santa.
En Asís, Italia, se respira la santidad de grandes personajes que la habitaron y han dejado una estela de devoción.
Muchos jóvenes acuden a Asís, más que en plan de turismo, para reflexionar y orar sobre el sentido de su vida por el testimonio de grandes santos.



¡Peregrino!
¿Ya estás listo para el Jubileo 2025?
Solicita el catálogo y compra lo necesario para que nada te falte.


















































El Evangelio que nuestra Madre Iglesia celebra hoy, muestra el misterio profundísimo de las tentaciones enfrentadas por el Señor Jesús. Estas pruebas, el Señor Jesús, las venció mediante la interpretación verdadera de la Palabra de Dios, conducido y lleno del Espíritu (Lc 4, 1-13)
EL ENEMIGO PROBÓ A JESÚS; POR EL CONTRARIO, EL ESPÍRITU LO IMPULSÓ DESDE SU INTERIOR
Jesús conducido por el Espíritu “se internó en el desierto, donde permaneció durante cuarenta días y fue tentado por el demonio” (vv. 1-2a). En el desierto se dieron cita el misterio del mal y el misterio del bien. En el desierto, lugar de soledad, vivió Jesús la espantosa experiencia del vacío: “No comió nada en aquellos días, y cuando se completaron sintió hambre” (v. 2b). ¡Nuestra fe cristiana vibra en el entrañable misterio de la humildad del hombre venido de Dios! (compárese Jn, 1, 1-14)
El enemigo probó a Jesús; por el contrario, el Espíritu lo impulsó desde su interior.
JESÚS, LLENO DEL ESPÍRITU, INTERPRETÓ CON VERDAD LA PALABRA DE DIOS
El demonio, se propuso, entonces, trastornar las buenas relaciones entre Dios y Jesús, y empezó por servirse del hambre como tentación (véase v. 3). Pero Jesús recurrió a la Palabra de Dios y le contestó: “Está escrito: ‘No sólo de pan vive el hombre’” (v. 4).
El demonio, príncipe del engaño, lo llevó después hacia una altura y le mostró todos los reinos, prometiendo entregárselos si se postraba delante de él (véanse vv. 5-7). De nuevo Jesús libró la tentación acudiendo a la Palabra de Dios: “Esta escrito: ‘Adorarás al Señor, tu Dios, y a Él sólo servirás’” (v. 8).
El demonio, el gran confusor, por último, lo condujo a Jerusalén a la parte más alta del templo y haciendo mal uso de la Palabra de Dios tentó a Jesús (véanse vv.9- 10). El sentido de la Sagrada Escritura es torcido
por el demonio, pero Jesús interpretando con verdad la Palabra de Dios y, lleno del Espíritu, respondió:
“No tentarás al Señor, tu Dios” (v. 12).
LA OBEDIENCIA Y LA HUMILLACIÓN ES EL CAMINO DE JESÚS
San Lucas, el autor del tercer evangelio, muestra así que Jesús: el Mesías y Siervo de Dios, se negó aceptar tentar a Dios, pues comprendió que la obediencia y la humillación eran el camino que tenía que recorrer.
Los invito a iniciar la Cuaresma, siguiendo el ejemplo de Jesús, quien recurrió a la Sagrada Escritura como escudo ante la tentación, tomando conciencia cómo Dios desplegó su providente solicitud, mediante las frases de la Escritura anidadas en la memoria fiel de Jesús, a través del Espíritu que actúa en su interior: “La letra mata, mas el Espíritu da vida” (II Co 3, 6).

BANCOMER
CREATOR COMUNICACIÓN, S DE RL. DE CV. PERIODICO SEMANARIO
CUENTA PARA DEPOSITOS
01 58 98 90 44
INTERBANCARIA (TRANSFERENCIAS)
01 23 20 00 15 89 89 04 40